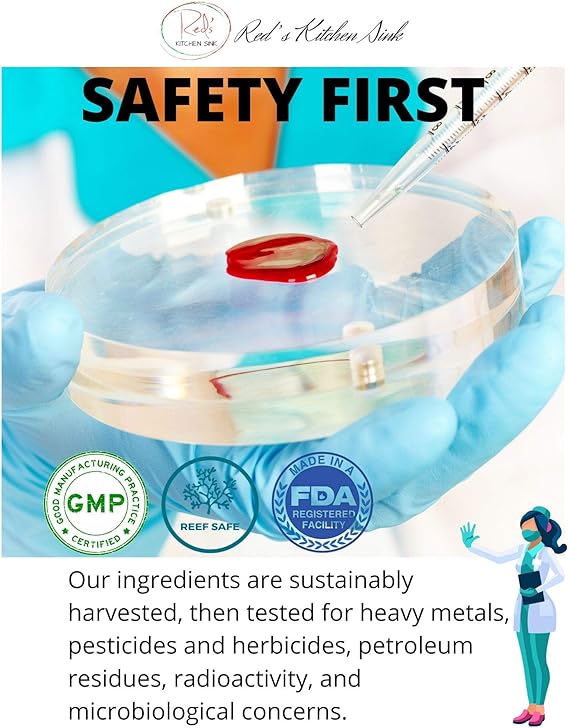
Red's Kitchen Sink Cell Fuel 102 Powder

Red's Kitchen Sink Cell Fuel 102 Powder
$4199
Unit price
/
Unavailable
Red's Kitchen Sink Cell Fuel 102 Powder is backordered and will ship as soon as it is back in stock.
Couldn't load pickup availability
Description
Description
Red's Kitchen Sink Cell Fuel 102 Powder
- ✅ INCREDIBLE & POWERFUL TRIO - Cell Fuel 102 contains a potent combination of blood burdock powder. This Dr. Sebi inspired blend is believed to contain over 102 minerals, vitamins and nutrients.
- ✅ NUTRIENT-RICH SUPPORT - Sea Moss Bladder Burdock Root is known for its rich nutrient profiles including vitamins, minerals, and antioxidants. This incredible combination offers a comprehensive nutritional boost including iron, magnesium, phosphorus, zinc, selenium, calcium, potassium, sulfur, silica, and more.
- ✅ Our Sea Moss Powder is Vegan, Gluten Free, Non-GMO - We have created this product to meet various dietary preferences and needs of our customers. Our proprietary blend is suitable for vegans.
- ✅ TRUSTED BRAND: Reds Kitchen Sink is committed to quality and safety. Our organic sea moss powder is made in the USA with globally sourced ingredients, in an FDA registered facility, and third-party tested.
- ✅ CONVENIENCE - Our Irish Sea Moss Powder is a great way to get your daily nutrition compared to making sea moss gel or eating sea moss gummies that are full of sugars and other unwanted ingredients. Please note that this herbal blend is unflavored and will have a sea-like smell and taste.